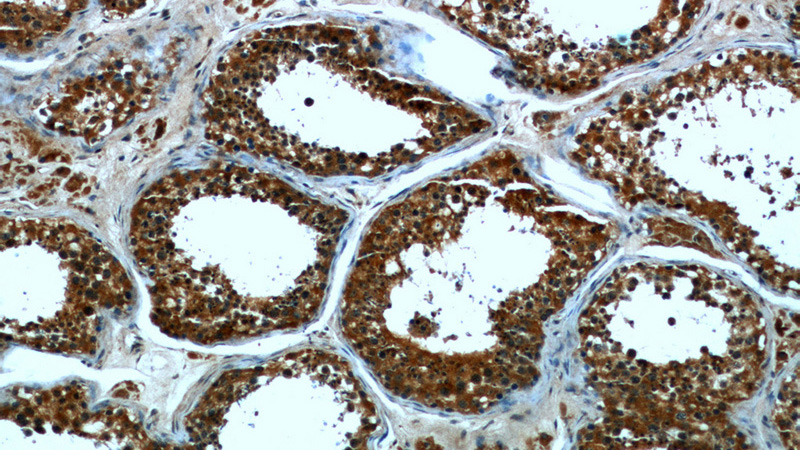
Immunohistochemical of paraffin-embedded human testis using Catalog No:107174(CPT1C antibody) at dilution of 1:50 (under 10x lens)
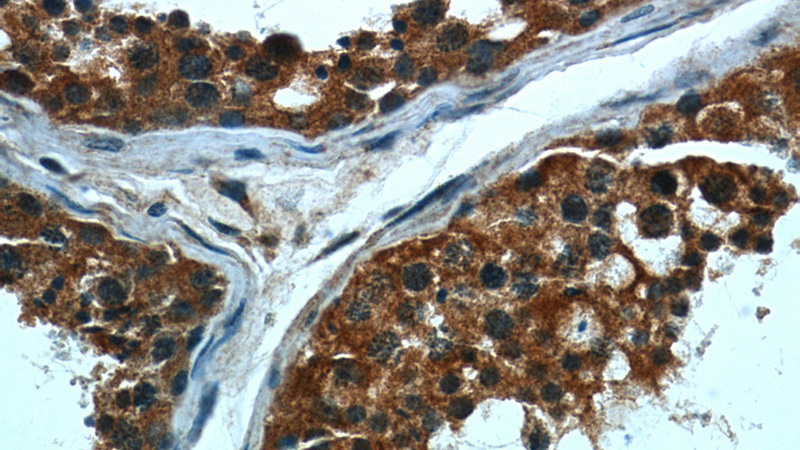
Immunohistochemical of paraffin-embedded human testis using Catalog No:107174(CPT1C antibody) at dilution of 1:50 (under 40x lens)

-
Product Name
CPT1C antibody
- Documents
-
Description
CPT1C Mouse Monoclonal antibody. Positive IHC detected in human testis. Positive WB detected in Human brain. Observed molecular weight by Western-blot: 82kD
-
Tested applications
ELISA, WB, IHC
-
Species reactivity
human; other species not tested.
-
Alternative names
CPT1C antibody; CPTI B antibody; CPT1P antibody; CPT1 B antibody; CPT IC antibody
-
Isotype
Mouse IgG2b
-
Preparation
This antibody was obtained by immunization of CPT1C recombinant protein (Accession Number: XM_047438159). Purification method: Protein A purified.
-
Clonality
Monoclonal
-
Formulation
PBS with 0.02% sodium azide and 50% glycerol pH 7.3.
-
Storage instructions
Store at -20℃. DO NOT ALIQUOT
-
Applications
Recommended Dilution:
WB: 1:200-1:2000
IHC: 1:20-1:200
-
Validations

human brain tissue were subjected to SDS PAGE followed by western blot with Catalog No:107174(CPT1C antibody) at dilution of 1:500
Immunohistochemical of paraffin-embedded human testis using Catalog No:107174(CPT1C antibody) at dilution of 1:50 (under 10x lens)
Immunohistochemical of paraffin-embedded human testis using Catalog No:107174(CPT1C antibody) at dilution of 1:50 (under 40x lens)
-
Background
CPT1C, also named as CATL1, CPTI-B and B-CPTI, belongs to the carnitine/choline acetyltransferase family. Carnitine palmitoyltransferase (CPT) deficiencies are common disorders of mitochondrial fatty acid oxidation. The CPT system is made up of two separate proteins located in the outer (CPT1) and inner (CPT2) mitochondrial membranes. CPT1C is an active forms of related brain-type carnitine palmitoyltransferase I. CPT1C may be a regulated target of malonyl-CoA that relays the “malonyl-CoA signal” in hypothalamic neurons that express the orexigenic and anorexigenic neuropeptides that regulate food intake and peripheral energy expenditure. (PMID: 17018521 ) This antibody can bind the close sequences genes.
Related Products / Services
Please note: All products are "FOR RESEARCH USE ONLY AND ARE NOT INTENDED FOR DIAGNOSTIC OR THERAPEUTIC USE"
